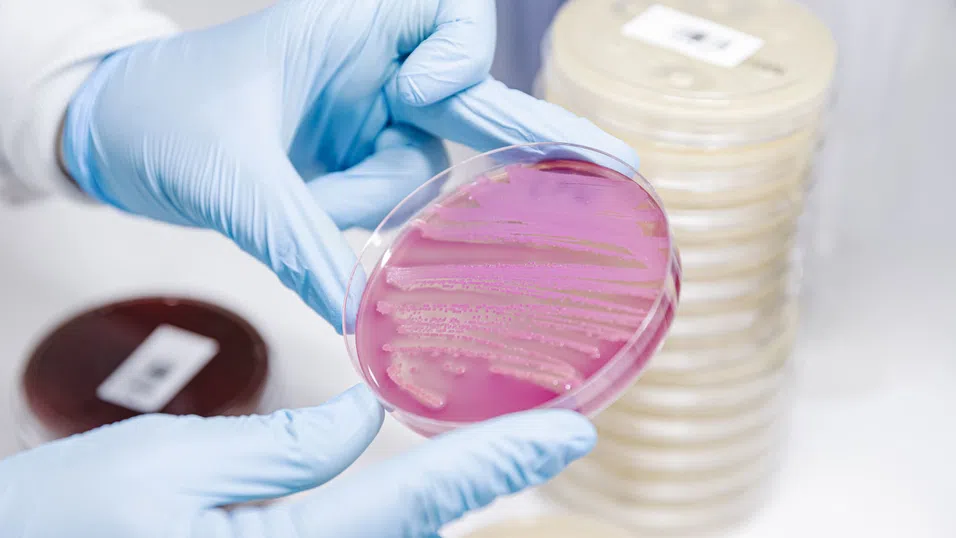
AI разработва антибиотици за гонорея и супербактерии

AI разработва антибиотици за гонорея и супербактерии
Лекарствата са тествани върху бактерии и заразени мишки, но предстоят още много години на клинични изпитвания преди да бъдат предписвани на хора.
&format=webp)
Изкуственият интелект е измислил два нови антибиотика, които могат да убият резистентната на лекарства гонорея и резистентен щам на стафилококова бактерия, разкриват изследователи.
Лекарствата са проектирани на молекулярно ниво от AI и са унищожили супербактериите в лабораторни и животински тестове, съобщава BBC. Двете съединения все още се нуждаят от години на усъвършенстване и клинични изпитвания, преди да могат да бъдат предписвани на хора.
Но екипът от Масачузетския технологичен институт (MIT), който стои зад откритията, твърди, че изкуственият интелект може да постави началото на „втора златна ера“ в откриването на антибиотици.
Инфекциите, които са резистентни към лечение, вече причиняват над един милион смъртни случая годишно. Прекомерната употреба на антибиотици е спомогнала за еволюцията на бактериите, които са се научили да избягват ефекта на лекарствата. От десетилетия насам има и недостиг на нови антибиотици.
Учените вече са използвали изкуствен интелект, за да прегледат хиляди известни химични вещества в опит да идентифицират тези, които имат потенциал да се превърнат в нови антибиотици.
Сега екипът от MIT е направил още една крачка напред, като използва AI, за да проектира антибиотици за полово предаваната инфекция гонорея и за потенциално смъртоносния метицилин-резистентен стафилокок (MRSA). Проучването им, публикувано в списанието Cell, изследва 36 милиона съединения, включително такива, които не съществуват или все още не са открити.
Учените обучават изкуствения интелект, като му предоставят химичната структура на известни съединения, заедно с данни за това дали те забавят растежа на различни видове бактерии. След това AI научава как бактериите се влияят от различни молекулни структури, изградени от атоми като въглерод, кислород, водород и азот.
Проведени са опити с два различни подхода за проектиране на нови антибиотици. Първият идентифицира обещаваща отправна точка, като претърсва библиотека от милиони химични фрагменти с размер от 8 до 19 атома, и продължава да работи оттам. Вторият дава на AI пълна свобода от самото начало.
Процесът на проектиране също така отсява всичко, което изглеждаше твърде подобно на вече съществуващите антибиотици. Той се опитва и да гарантира, че се измислят нови лекарства, а не химични вещества с друг вид приложение.
Учените използват изкуствения интелект, за да създадат антибиотици за гонорея и MRSA – щам на стафилококова бактерия, който живее безвредно върху кожата, но може да причини сериозна инфекция, ако попадне в организма.
След производството им, най-обещаващите химични съединения се тестват върху бактерии и заразени мишки в лаборатория. В резултат са получени две нови потенциални лекарства.
„Ние сме развълнувани, защото показахме, че AI може да се използва за проектиране на напълно нови антибиотици“, казва проф. Джеймс Колинс от MIT пред BBC.
„Изкуственият интелект ни позволява да създаваме молекули евтино и бързо и по този начин да разширим арсенала си и да спечелим предимство в битката срещу супербактериите.“
Те обаче все още не са готови за клинични изпитвания. Лекарствата ще трябва да бъдат усъвършенствани, което вероятно ще отнеме още една до две години работа. Едва тогава може да започне дългият процес на тестване върху хора.
Д-р Андрю Едуардс от Fleming Initiative и Imperial College London твърди, че работата е „много значима“ и има „огромен потенциал“, защото „демонстрира иновативен подход към разработването на нови антибиотици“.
„Макар изкуственият интелект да обещава драстично подобрение, все още ни предстои много работа по тестването на безопасността и ефикасността“, допълва той.
Това може да бъде дълъг и скъп процес, без гаранция, че експерименталните лекарства ще бъдат предписани на пациенти в крайна сметка.
Някои призовават за по-широко подобрение в откриването на лекарства с помощта на AI. Проф. Колинс подчертава, че „имаме нужда от по-добри модели“, които да предсказват по-добре ефективността на лекарствата в организма.
Съществува и проблем с това колко трудни за производство са проектите, създадени с изкуствен интелект. От 80-те най-добри теоретични проекта за лечение на гонорея само два са превърнати в лекарства.
Проф. Крис Даусън от Университета на Уоруик коментира, че проучването е „страхотно“ и показва, че изкуственият интелект е „значителен напредък като инструмент за създаване на антибиотици, които да намалят появата на резистентност“.
Въпреки това, той обяснява, че има и икономически проблем, свързан с резистентните към лекарства инфекции – „как да произвеждаш лекарства, които нямат търговска стойност?“
Ако бъде изобретен нов антибиотик, в идеалния случай той би трябвало да се използва колкото се може по-малко, за да се запази ефективността му, което би затруднило печалбата от него.



)



&format=webp)
&format=webp)
&format=webp)
&format=webp)
&format=webp)
&format=webp)
&format=webp)
&format=webp)